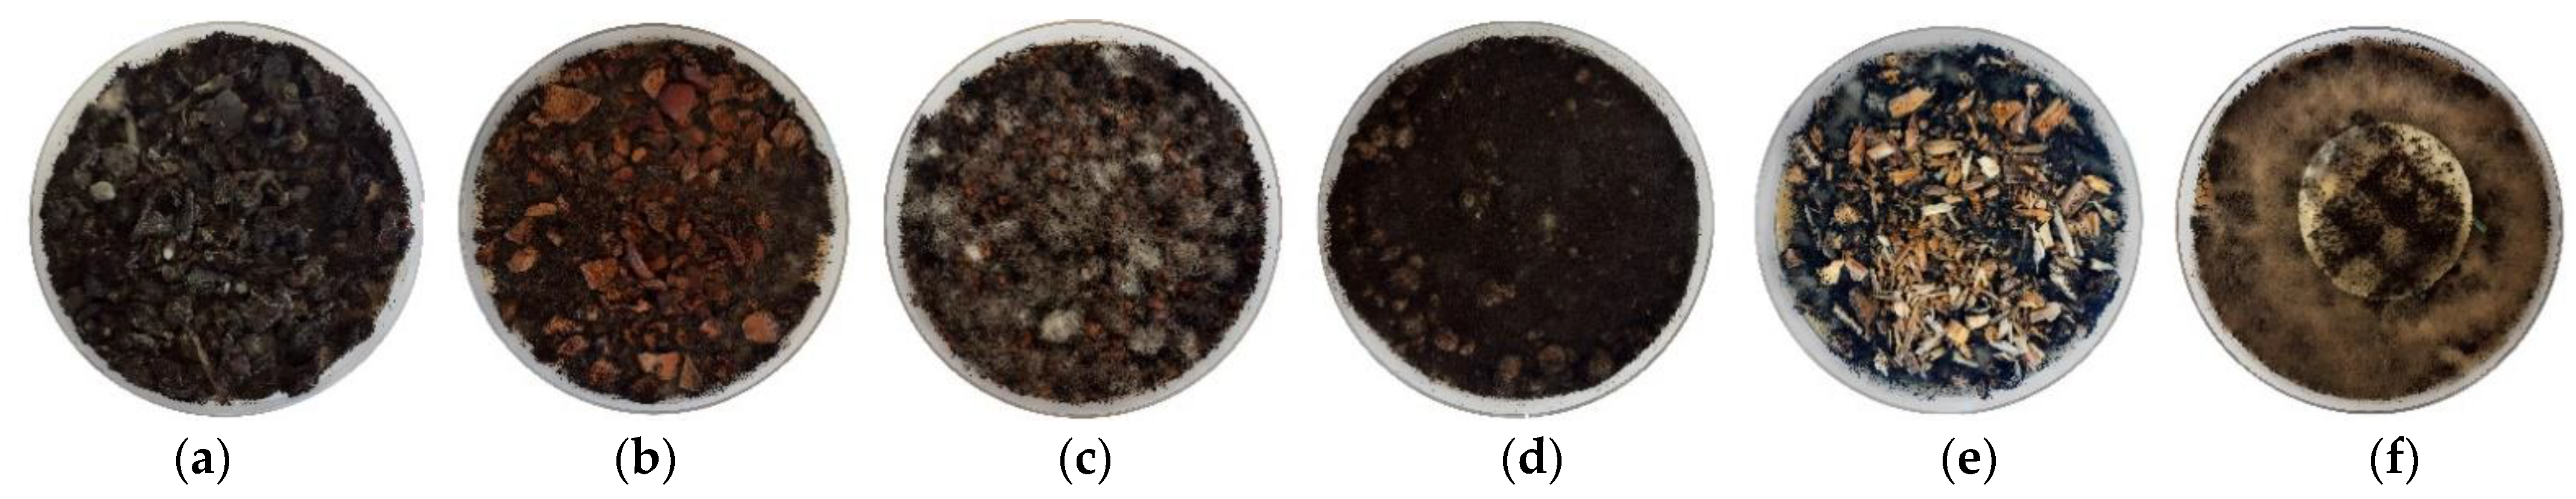
Infrastructures 07 00026 g009
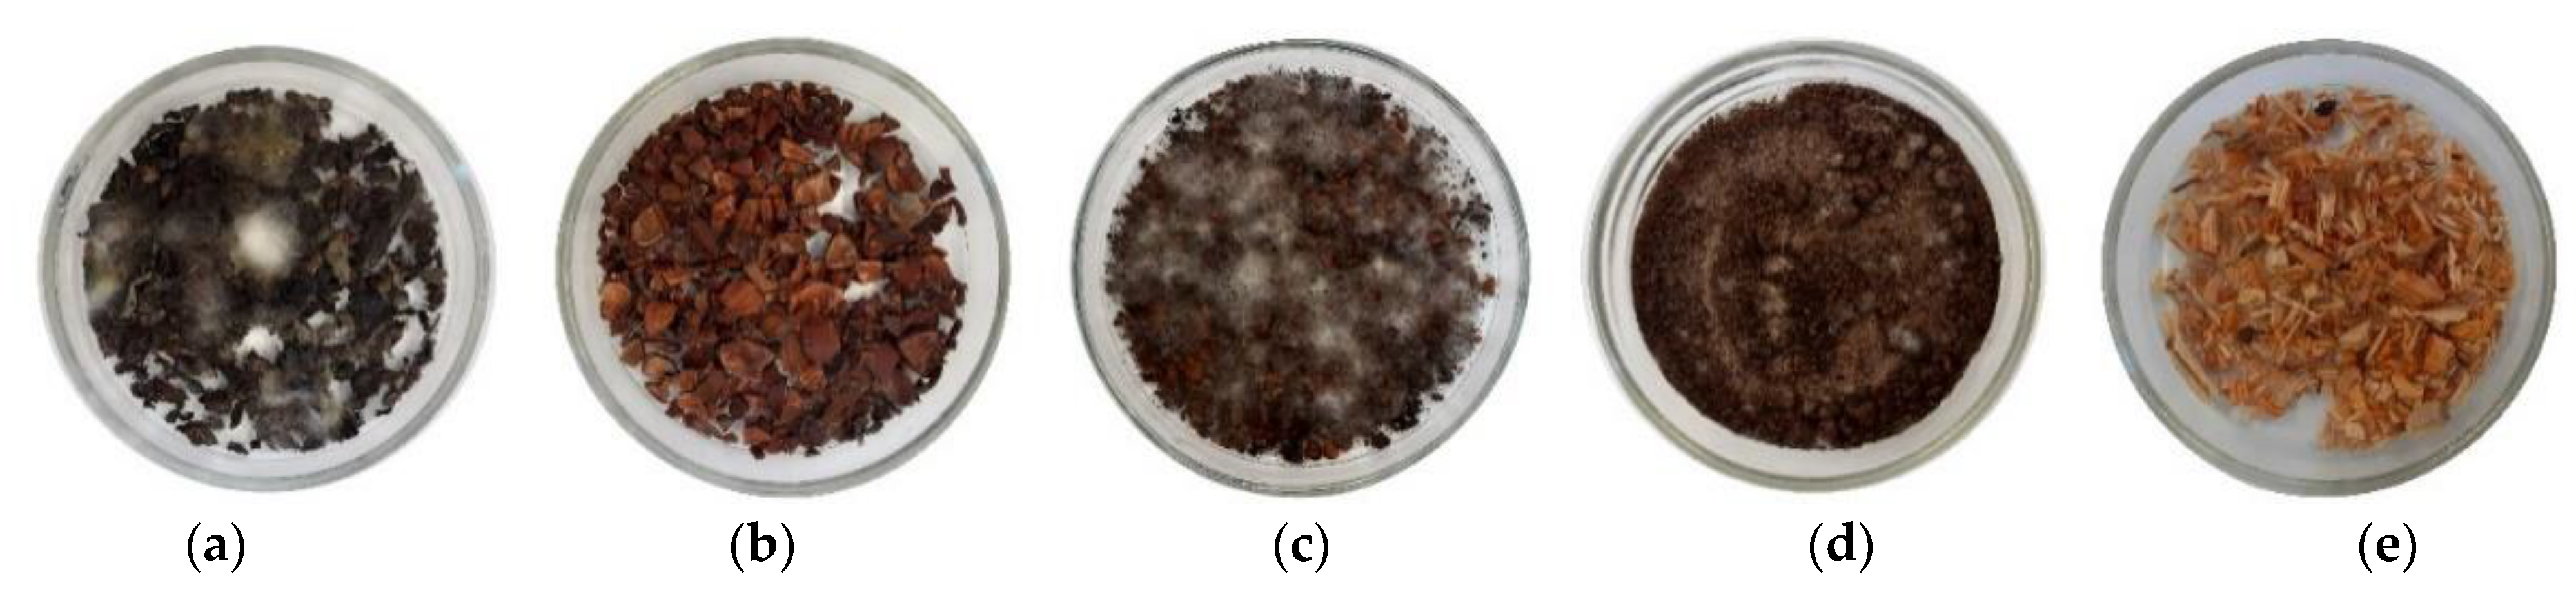
Infrastructures 07 00026 g010

3.2. Loose Bulk Density and Thermal Conductivity
Table 4 reports the results of loose bulk density of the bio-wastes analysed by the two methods, comparing them with literature values.
Values of the considered bio-wastes have the same order of magnitude of literature ones. The main differences derive from different types and particle sizes that widely affects the values of loose bulk density [
58]. Wood chips show the lowest values of loose bulk density, as expected. Grape press waste could be the best aggregate to produce thermal insulation boards since it has the lowest loose bulk density value between the bio-wastes.
Table 4.
Measured loose bulk density of the analysed bio-wastes and comparison with literature values.
Table 4.
Measured loose bulk density of the analysed bio-wastes and comparison with literature values.
| Material | Loose Bulk Density (kg/m3) | Literature Values (kg/m3) | Reference |
|---|
| According to Amziane et al. [30] | According to EN 1097-3 [47] |
|---|
| Grapes press waste | 343.88 ± 12.00 | 325.60 ± 5.82 | 105 ± 5 a | Wong et al. [18] |
| 1449 ± 2 b | David et al. [59] |
| 1420 ± 3 c | David et al. [59] |
| Hazelnut shells | 550.50 ± 19.53 | 549.66 ± 11.92 | 230 | Çöpür et al. [60] |
| Olive press waste | 449.43 ± 8.60 | 427.32 ± 9.62 | 1251 d | Liuzzi et al. [61] |
| 616 e | del Río Merino et al. [62] |
| Spent coffee grounds | 478.81 ± 5.40 | 447.73 ± 5.13 | 380 ± 20 f | Massaro Sousa and Ferreira [63] |
| Wood chips | 256.98 ± 8.10 | 250.20 ± 4.59 | 130 ± 2 g | Wong et al. [18] |
Considering the materials chosen for comparison, granular cork waste derived from cork panels, bottles cap manufacturing, cork industry (not expanded cork) showed values of about 150–160 kg/m
3 [
64]. For expanded cork granulate, Brás et al. [
65] reported values of 112 kg/m
3 and Nóvoa et al. [
66] values of 220 kg/m
3. For corn cob, Ansell et al. [
58] obtained values of about 344–406 kg/m
3. Laborel-Préneron et al. [
32] evaluated corn cob and hemp shiv, achieving results of 497 kg/m
3 and 153 kg/m
3, respectively. For hemp shiv, Page et al. [
31] reported values of 110 kg/m
3. Antunes et al. [
33] studied rice husk, reporting a loose bulk density of 85 kg/m
3. The selected bio-wastes have a higher loose bulk density, except for corn cob evaluated by Laborel-Préneron et al. [
32]. In this case, only hazelnut shells show higher values. Grape press waste has a loose bulk density closer to the one of corn cob evaluated by Ansell et al. [
58].
Table 5 shows the values of thermal conductivity of the analysed bio-wastes. The thermal conductivity values are higher than the required to consider a material as thermal insulation, namely not lower than 0.065 W/(m·K) [
15]. None of the tested bio-wastes can be classified as such. To produce boards with good thermal resistance using these bio-aggregates, it will be necessary to combine them with other materials with good thermal insulation properties or produce them in a way that air is entrapped within the composite in small volumes. Grape press waste has the lowest thermal conductivity, similar to one of the wood chips: it seems the most promising bio-aggregates to produce composites with good thermal insulation performance. Taking into account the correlation with loose bulk density, thermal conductivity values are in line with the expected since there is a direct proportionality [
67]. Hazelnut shells have the worst thermal insulation behaviour (the highest thermal conductivity), having the highest loose bulk density; grape press wastes and maritime pine chips show the lowest values of thermal conductivity, having the lowest values of loose bulk density.
Considering the materials chosen for comparison, all the bio-wastes have higher values of thermal conductivity, except for the one of corn cob. However, the test conditions of temperature and RH are frequently not defined.
Figure 4 and
Figure 5 show the correlations between thermal conductivity and RH, and between thermal conductivity and loose bulk density. As expected, the thermal conductivity increases proportionally to RH and the loose bulk density, for all tested bio-wastes.
Figure 5 also reports the values of the materials chosen for comparison, being the lower thermal conductivity justified by lower loose bulk density.
Gomes et al. [
70] and Cherki et al. [
64] reported values of thermal conductivity of expanded granular cork of about 0.035–0.070 W/(m·K) and 0.049–0.050 W/(m·K), respectively. For hemp shiv, Laborel-Préneron et al. [
32] reported values of 0.051 W/(m·K) while Page et al. [
31] of 0.048 W/(m·K). Antunes et al. [
33] evaluating rice husk achieved results of about 0.047 W/(m·K). Comparing with the results of Laborel-Préneron et al. [
32], among the tested bio-wastes only hazelnut shells have a higher thermal conductivity than corn cob’s one (0.096 W/(m·K)). Considering the results of Ansell et al. [
58], the thermal conductivity of corn cob (0.085 W/(m·K)) is higher than grape press waste and wood chips. Despite these results, the analysed bio-wastes may be used as bio-aggregates for insulation composite boards and panels’ production, if the composition and methods are able to improve the insulation performance.
3.3. Water Absorption and Sorption/Desorption Properties
Figure 6 reports the results of water absorption of the five studied bio-wastes considering the method proposed by Amziane et al. [
30], and
Table 6 presents the water absorption after 48 h.
Except for the spent coffee grounds, the analysed bio-wastes show a similar behaviour along time (
Figure 6), starting to saturate after approx. 4 h of immersion, although with different levels of water absorption. Comparing with past studies [
32,
33], the correlation between water absorption and time is similar.
Regarding the absorption after 48 h (2880 min,
Table 6), the different percentages can be observed. The results were compared with some literature ones determined by the same method [
30]. Laborel-Préneron et al. [
32] reported that water absorption after 48 h for corn cob is 123% and 380% for hemp shiv. Page et al. [
31] obtained values of about 450% for hemp shiv. Antunes et al. [
33] of about 300% for rice husk.
Values of water absorption of the analysed bio-waste are lower than in the literature. The discrepancy is probably caused by the considered method that could lead to differences in the results: the used permeable bags could be different, an eventual compaction of the materials during the permeable bag’s closing or inside the bags, as well as the compaction of the material during the absorbing phase and the manual rotation speed. To ensure a direct comparison between different materials, the method should be complemented. For example, the opening mesh of the permeable bag should be defined according to the grain size of the bio-aggregates, or the rotation time could be controlled automatically to avoid manual operation mistakes. Another important factor that could influence the water absorption capacity is the temperature of the water, as demonstrated by Bouasker et al. [
71].
Most materials absorb a greater quantity of water during the first 24 h. Hazelnut shells show the lowest water saturation content. They achieved the lowest value of water absorption after 24 h (32.9 ± 2.6)%, followed by olive press waste (48.9 ± 1.6)%. Wood chips and grape press waste show the highest values of water absorption after the first 24 h ((101.9 ± 1.6)% and (88.0 ± 0.7)%, respectively).
Information about water absorption is extremely useful for future boards’ production in case of using a hydraulic matrix, as Laborel-Préneron et al. [
32] reported. To better investigate this property, the ratio between the volume of absorbed water and the volume of the materials was calculated and its evolution with time is reported in
Figure 7.
Supposing to produce boards or panels by wet methods and by defining the percentages of the components in volumes, with the same quantities of bio-wastes, composites with hazelnut shells should absorb less water. Composites with grape press waste will probably need more water for production than the others to obtain the same workability because more water will be absorbed by the bio-wastes.
Figure 7 also shows that, differently from the evaluation of water absorption in terms of mass, wood chips show lower water absorption than grapes press waste. Again, the performance of spent coffee grounds differs greatly from the other bio-wastes. This one shows a slower water absorption: after 120 h it is still absorbing water and the constant mass is reached only after 10 days. The difference between spent coffee grounds and the other bio-wastes may depend on the different grain sizes but other characteristics of the coffee grounds may also have influence.
Figure 8 shows the variation in moisture adsorbed/desorbed content over time for the considered bio-wastes.
As Collet [
56] and Romano et al. [
72] reported, hygroscopicity properties widely affect the thermal behaviour of the composites and the control of the dynamic moisture changes. MBV values show the potential of bio-aggregates as hygric regulators [
58]. For these reasons, the obtained results could anticipate some of the future properties of the boards.
Olive press waste achieved the highest values of moisture adsorption (ρA,ac between 0.114 kg/m2 and 0.116 kg/m2) and desorption content (ρA,ad between 0.104 kg/m2 and 0.113 kg/m2) during the four cycles. Wood chips and hazelnut shells reached the lowest values both in the sorption and desorption phases. Values of moisture sorption are between 0.076 kg/m2 and 0.080 kg/m2 for wood chips, between 0.078 kg/m2 and 0.083 kg/m2 for hazelnut shells. As for desorption, the values are between 0.074 kg/m2 and 0.078 kg/m2 and between 0.074 kg/m2 and 0.077 kg/m2, respectively.
Considering the moisture content difference between sorption and desorption, ρA,sc, values of grape press waste, olives press waste and wood chips are close to zero during the first cycle (between −0.001 kg/m2 and 0.001 kg/m2). Hence, these aggregates have similar sorption and desorption capacity. The first cycle shows not already stabilized bio-wastes moisture capacity. Except for wood chips and spent coffee grounds, sorption capacity is greater than desorption. During the second cycle, the bio-wastes sorption capacity improved. For all the bio-wastes, moisture adsorption content, ρA,ac, is greater than moisture desorption content, ρA,ad. After the first cycle, also for spent coffee grounds the moisture content difference is near to zero (maximum value of 0.001 kg/m2). Hazelnut shells showed the greatest moisture content difference for all the cycles (values between 0.004 kg/m2 and 0.006 kg/m2), with higher moisture sorption capacity than desorption.
However, the moisture content differences are very small for all the bio-wastes and during all cycles, less than 0.01 kg/m
2. Furthermore, the measurement method (opening and closing of the climatic chamber) might have determined an error that has to be taken into consideration. As Romano et al. [
72] reported, the difference between the bio-wastes might depend on a micro-capillary network formation that is created during water molecules sorption/desorption.
Table 7 reported MBV values [g/(m
2·% RH)] and the classification provided by Rode et al. [
49]: Negligible: MBV = 0.0–0.2; Limited: MBV = 0.2–0.5; Moderate: MBV = 0.5–1.0; Good: MBV = 1.0–2.0; Excellent: MBV ≥ 2.0. MBV. Values were calculated to allow a comparison between the bio-wastes and other already studied materials. Indeed, a gap in literature did not allow a comparison to be made between the variation in sorption/desorption content during time of the analysed materials and the ones considered for comparison evaluated by the same test.
Olive press waste showed the highest MBV, the wood chips and the hazelnut shells had the lowest ones. In composites’ production, olives press waste might guarantee a greater sorption/desorption capacity. They could therefore be the worst aggregates to produce thermal insulation boards, but the best ones in the case of indoor coating panels. Indeed, a high moisture buffering capacity can contribute to the passive control of the internal conditions and indoor air quality. However, these considerations should be verified: the performance of the composites widely varies depending on the complementary components (binders, additives) and the production method. Future studies should be devoted to determining the properties of these bio-wastes when combined with other materials to produce building composites. Overall, even in case of performances worse than the ones of typical composites, the use of bio-wastes replacing raw materials may offer a competitive and more sustainable solution than other common ones. Furthermore, it would be interesting to investigate the relationship between the bio-aggregates and composites’ properties.
According to Ansell et al. [
58], a correlation of linear proportionality was expected between loose bulk density and MBV values for natural fibres. They showed that MBV increased with bulk density for hemp shiv, flax shiv, wheat straw and rape shiv. Holcroft and Shea [
73] obtained different results considering hemp-lime: the lower the density, the higher the MBV. In the present study, the comparison between the materials does not allow defining a correlation between loose bulk density and MBV. MBV varies depending on other parameters too (e.g., grain size, chemical composition). Cintura et al. [
10] reported chemical compositions of the analysed bio-wastes by considering past studies. The researchers accounted it as an important parameter that influences materials’ physical and mechanical features. They supposed that the selected bio-wastes may have good moisture buffering capacity, confirmed by the results of the present study.
Considering literature values of some of the materials chosen for comparison, corn cob showed values of 3.24 g/(m
2·% RH) [
58], higher only than hazelnut shells’ ones. Hemp shiv had values of about 2.09–2.53 g/(m
2·% RH) [
58], lower than the ones of all analysed bio-wastes. This demonstrates that the selected bio-wastes have good hygroscopicity behaviour. It might be a drawback for insulation boards production, even if, as anticipated, the performances will depend on the final compositions.
3.4. Bio Susceptibility to Mould and Termites
Figure 9 gives an idea of the mould growth over the five materials and the control when inoculated with culture media and after four weeks.
All the analysed bio-wastes with culture media are highly susceptible to mould attack, as expected. They reached the maximum value (4-contaminated surface more than 60%) during the second week of testing. The culture media contributes to the biological attack by increasing the sugar content available to the fungi. The controls (
Figure 9f) demonstrated the validity of the test; all replicates reached grade 4 also on the second week of exposure.
Table 8 reports the results of weekly mould growth for the samples without culture media and
Figure 10 shows the materials after four weeks of exposure.
Even without surrounding the culture media, all the analysed bio-wastes have a high susceptibility to mould. Differently from the previous results, the samples reached the maximum value during the third week of testing, confirming the higher susceptibility caused by culture media (
Figure 9). The biological attack of the controls (
Figure 10e) demonstrated the validity of the test: being wood chips, mould growth was expected. They were rated as 2.70 (contaminated surface between 30% and 60%) after four weeks, hence all the bio-wastes showed a lower biological resistance.
Hazelnut shells showed similar behaviour to control during the first week, being both rated as 0.4. Nonetheless, this bio-waste reached the maximum values at the end of testing as the others. Grape and olive press waste showed the lowest resistance to mould, being rated at 4 during the second week. Spent coffee grounds reached the maximum value during the third week. As previously anticipated, high hygroscopicity improves mould growth. Considering the results of water adsorption, they could be considered consistent with the bio susceptibility ones: olives and grapes press waste showed the highest moisture buffering capacity, hazelnut shells and wood chips the lowest one. However, considering only the correlation between hygroscopicity and biological attack is an oversimplification. Bio susceptibility depends also on many other factors such as materials’ composition, pH, surface properties, roughness, chemical and physical capabilities of mould species [
51,
74]. Mould growth could be further investigated since these laboratory tests aim at showing an initial assessment. The results confirm that, as bio-based materials, all the tested bio-wastes have a high susceptibility to mould.
Past research reported that caffeine improves the biological resistance of wood, lowering fungal growth. Kwaśniewska-Sip et al. [
75] diluted caffeine into a water solution to treat Scots pine (
Pinus sylvestris L.) samples; Šimůnková et al. [
76] considered Norway spruce (
Picea abies L. Karst.) samples. In both cases, caffeine solution improved wood’s biological resistance. Nevertheless, even if spent coffee grounds could be a source of chemicals that can moderate mould growth, they cannot be used to avoid the biological attack, as Barbero-López et al. [
77] reported. Indeed, the raw material is known as a good material to allow mould growth [
78,
79], as confirmed also in the present study.
Table 9 reports the results related to the susceptibility to subterranean termites, considering the average value for each bio-waste. The survival rate of the maritime pine (higher than 50%) confirms the validity of the test.
Figure 11 shows the samples after the four weeks.
The termites were able to consume all bio-wastes, though their ability to survive was highly influenced by both the available cellulose they could use and the fast development of moulds that they were not able to limit. The bio-waste with the highest amount of cellulose (grape press waste with small parts of grapevine) [
10] was not surprisingly the most consumed by termites and the one that kept the highest survival rate of the termites during the test period. Hazelnut shells have better resistance to termites than wood chips, but they are not completely unaffected: 10.67% of the termites survived deteriorating a part of the material. Cintura et al. [
10] reported that hazelnut shells have a cellulose content of about 22.90−34.60%. According to past studies, wood chips have a cellulose content of about 32.09–50.00% [
80,
81,
82]. The results are in line with this information: termites probably fed on hazelnut shells, but the cellulose content, i.e., the necessary nutrients to survive, was not enough, hence they slowly died.
Termites’ survival for spent coffee grounds and olives press waste was rated at 0%, but these results cannot be considered as a demonstration of their best resistance to termites. Indeed, these materials also showed a high mould growth (
Table 9 and
Figure 11a,d) that could be the cause of termites’ mortality. Šimůnková et al. [
76] investigated caffeine’s resistance from termites, applying a caffeine and water solution on wood and exposing the samples to
Reticulitermes flavipes (Kollar). The results of their study demonstrated that caffeine improves the biological resistance of wood. Nevertheless, as previously anticipated, this cannot demonstrate good resistance to termites of spent coffee grounds. As Cintura et al. [
10] reported, collecting information from several past studies, cellulose content in this bio-waste is between 8.60–52.42%. The range of variation is high, but spent coffee grounds have the lowest values when compared with the other considered bio-wastes. This information and the results of the present work cannot confirm a high termite resistance with spent coffee grounds, also due to the mould formation during the four weeks. Maybe this bio-waste could be used as a source of caffeine to apply on future eco-efficient boards/panels.
3.5. Comparison between Bio-Wastes and Wood Chips
As previously anticipated, maritime pine chips were considered as control material.
Table 10 reports a comparison between the properties of the bio-wastes and wood chips, considering their use as thermal insulation materials. It shows which properties could be considered better (in green) or worse (in orange) than maritime pine ones for thermal insulation boards. The maximum/minimum values are highlighted with stronger shades of green/orange. When they are not highlighted, there is no difference between the considered bio-waste and wood chips. When they are highlighted in grey, more considerations have to be made. It is important to remind that this work presents some screening tests and properties of bio-aggregates. The performance of the final composites will widely depend on their composition and production method.
The analysed bio-wastes have higher values of loose bulk density and thermal conductivity than maritime pine chips. This may result in composites with worse thermal insulating performances than wood-based ones. A higher loose bulk density of the aggregates could be a drawback for thermal insulation boards’ production, a benefit in case of coating panels’. The values of absorption capacity after 48 h are lower for the selected bio-wastes; hence, they may secure a higher water resistance when used in composites. For MBV, the values are higher than wood chips’ ones, except for hazelnut shells. It seems that composites produced with the bio-wastes could have a higher contribution as moisture regulators than wood-based ones, guaranteeing better passive equilibrium of indoor humidity levels. This could be a benefit in case of internal coating panels’ production, and a drawback in case of external panels or thermal insulation boards. A high MBV could affect the durability of the building composites. In terms of bio-susceptibility, the analysed bio-wastes show low resistance to mould, as well as wood chips. For termites, the outcomes of spent coffee grounds and olive press waste cannot be considered as a demonstration of high resistance: they could result from mould growth. Hazelnut shells show better resistance to termites’ attacks than wood chips, but they are not completely unaffected. For eco-efficient building products, this drawback should be further investigated and solved.
The comparison between bio-wastes allows concluding that grape press waste is the most similar to maritime pine chips. It may be a good replacement of wood particles in future boards’ production, even if many other factors play an important role (e.g., binders, production phase, treatments).
The final performance of panels and boards produced with the studied bio-wastes will strongly depend on their composition. The selected binders could both moderate or increase the benefits or the drawbacks of using these bio-wastes as aggregates. For example, for a hydraulic matrix, the use of water could cause the degradation of the bio-wastes and increase mould growth. Differently, a binder with a pH higher than 10 could guarantee less vulnerability to biological attack [
51]. The thermal insulation properties could be improved by using a binder that secures the bonding of the aggregates by leaving a porous network between them.
Furthermore, the use of additives and the mixture with other material may widely affect the properties of the final product. For example, citric acid can moderate biological susceptibility and water absorption [
83,
84,
85]. Past studies reported that boric acid, lime and potassium benzoate moderate mould growth [
37,
86,
87]. On the other hand, they might increase the values of bulk density and thermal conductivity.
Pre-treatments of the bio-wastes may influence their properties, as Antunes et al. [
33] demonstrated. As for the production methods, the curing phases [
88] may be important, depending on the binder matrix. A fast and ventilated drying environment for the curing of the final product could avoid mould growth. Finally, the production process may widely affect the final properties. For example, pressing the composites increases bulk density and mechanical resistance, while just moulding could guarantee boards with lower bulk density and better thermal insulation properties.
Future studies could further investigate how all these parameters can influence eco-efficient boards and panels’ performance.